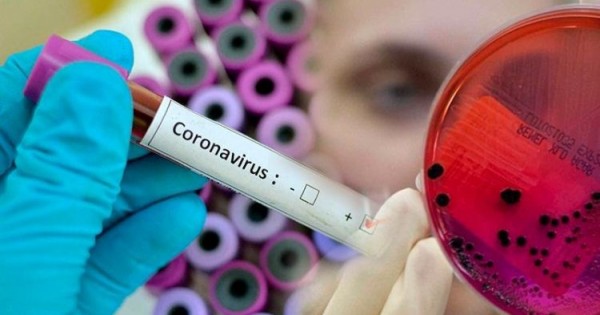

Vırýs juqtyrǵan 1989, 1996 jáne 2014 jylǵy 3 er azamat jáne 1983, 1994, 2005, 2006, 2006, 2012 jáne 2018 jylǵy 7 azamatsha ózine deıin vırýsty juqtyrǵan adamdarmen qarym-qatynasta bolǵan. Barlyǵy birden karantındik stasıonarǵa jatqyzylyp, zerthanalyq synama alynǵan. Naýqastardyń barlyǵy Qaraqııa aýdany Senek aýylynyń turǵyndary. PTR dıagnostıkalyq zertteý qorytyndysymen COVID-19 dıagnozy naqtylandy. Qazirgi tańda naýqastardyń jaǵdaıy qanaǵattanarlyq. Bekitilgen hattamaǵa sáıkes tıisti em júrgizilýde. Naýqaspen qarym-qatynasta bolǵan adamdar anyqtalyp, barlyǵy medısınalyq baqylaýǵa alynýda. Qazir Senek aýylynda tolyqtaı dezınfeksııalyq jumystar bastalyp ketti, delingen habarlamada.
29.04.2020 j. jaǵdaı boıynsha óńirde barlyǵy 44 adamnan COVID-19 vırýsy anyqtaldy. Aqtaýda – 18, Jańaózende – 5, Mańǵystaý aýdanynda – 4, Munaıly aýdanynda – 3, Qaraqııa aýdany – 14, jazylyp shyqqany – 7, qaıtys bolǵan – 1 adam.
Mańǵystaý oblysy



































